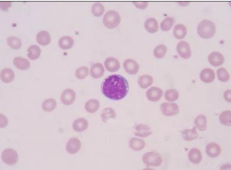

Class 12 Medical Diagnostics Sample Paper 2026 Solved
SECTION A: OBJECTIVE TYPE QUESTIONS
1. Answer any 4 out of the given 6 questions on Employability Skills (1 x 4 = 4 marks)
I. _____ is not a stage of active listening
a) Remembering
b) Responding
c) Respecting
d) Receiving
ii. What does S signify in SMART?
Ans: Specific
iii. What is the format of writing any function?
Ans: The format of writing any function in Calcis: =function_name(Argument1; Argument2; Argument3;…..
iv. Define creativity.
Ans: Creativity is a process of continually improving ideas and solutions by making gradual alterations and refinements. Entrepreneurs exhibit creativity by applying the process of design thinking, thinking of
alternatives, trying unconventional ways to do things, and continuously improvise and iterate.
v. Which of the following is an example of electric vehicle technologies hybridized with fossil fuel engines
(a) Battery cars
(b) Automatic vehicles
(c) PHEVs(Plug-in Hybrid Electric Vehicles)
(d) EEVs (Energy Efficiency Vehicles)
vi. _____ is used to find the average of numbers in a range of cell.
Ans: Average function
2. Answer any 5 out of the given 7 questions (1 x 5 = 5 marks)
i. Write down the full form of CBC.
a) Common blood count
b) Complete blood count
c) Complete bone count
d) Cytopathological blood count
ii. Name the anticoagulant that is best to use for coagulation studies.
Ans: Trisodium Citrate
iii. What do you mean by MCHC?
Ans: Mean corpuscular hemoglobin
iv. The purpose of using Glycerin for observing blood smear is-
a) Inhibiting growth of microorganisms
b) To make RBC settle on surface of counting chamber
c) To inhibit rouleaux formation
d) To stain nuclei of leukocytes.
v. In which condition decreased osmotic fragility is seen?
a) Congenital spherocytosis
b) Thalassemia
c) Autoimmune disorders
d) Cushing’s disease
vi. Write down the full form of PCV.
Ans: Packed cell volume
vii. Name the instrument to separate solution into sediment and supernatant by using required speed.
Ans: Centrifuge
3. Answer any 6 out of the given 7 questions (1 x 6 = 6 marks)
i. Name one commonly used method to measure ESR.
a) Benedict’s test method
b) Fehling’s test method
c) Westergren’s Method.
d) Romanowsky Method
ii. Reference range for calculating RBC count in females is –
a) 3.8-4.8 millions/cumm
b) 4.5-5.5 millions/cumm
c) 2.8-3.8 millions/cumm
d) 4.8-5.8 millions/cumm
iii. Which RBC diluting fluid is used if one wants to prevent rouleaux formation?
Ans: Gower’s solution
iv. What do you mean by Hematopoiesis?
a) An increase in platelet count
b) Production of blood cells
c) An increase in WBC count
d) An increase in RBC count
v. Who discovered Rhesus blood group system?
Ans: Land Steiner and Wiener
vi. The titer of an antibody is usually determined by testing two fold serial dilution of the serum against selected cells.
Ans: Red
vii. Rh antibody titres are done in the antenatal period –
a) Rh-positive mother with Rh-positive foetus may get alloimmunised with anti-D and cause hemolytic disease
b) Rh-positive mother with Rh-negative foetus may get alloimmunised with anti-D and cause hemolytic disease
c) Rh-negative mother with Rh-negative foetus may get alloimmunised with anti-D and cause hemolytic disease
d) Rh-negative mother with Rh-positive foetus may get alloimmunized with anti-D and cause hemolytic disease
4. Answer any 5 out of the given 6 questions (1 x 5 = 5 marks)
i. is defined as clumping of particles that have antigen on their surface and is brought about by antibodies.
a) Agglutination
b) Hemolysis
c) Reaction
d) Blood clot
ii. Which is the largest component of Biomedical Waste generated-
a) Radioactive waste
b) Hazardous waste
c) Non-hazardous waste
d) Infectious waste.
iii. are serum proteins, more specifically immunoglobulins.
a) Antigens
b) Antibodies
c) Pathogen
d) Haemocytes
iv. Romit has a platelet count of 104,000/microliter in his blood. He is suffering from condition called-
Ans: Thrombocytosis
v. What are the antigens of the Lutheran system?
a) Lu m and Lu n
b) Lu c and Lu d
c) Lu a and Lu b
d) Lu u and Lu v
vi. The two types of processes which can be done using a cell separator are-
a) Continuous and discontinuous flow processes
b) Continuous and interrupted flow processes
c) Controlled and uncontrolled flow processes
d) Balanced and unbalanced flow processes.
5. Answer any 5 out of the given 6 questions (1 x 5 = 5 marks)
i. What is the basic function of autoclave in laboratory?
Ans: Sterilization
ii. Exfoliative cytology does not deal with study of cells from
a) Epithelial and Mesothelial lining
b) Body fluids
c) Tissue fragments extracted from lesions
d) Bronchial washings and buccal smear
iii. Name one special-purpose fixative used in a cytology laboratory.
a) AAF fixative
b) Carnoy’s fixative
c) Formalin
d) Giemsa stains
iv. The preferred test for detecting cervical cancer is-
a) RT PCR
b) ELISA
c) PAP Smear
d) WIDAL Test
v. Name the chemical which is used for dehydration process.
Ans: Alcohol
vi. What do you mean by Cytology?
Ans: Study of cells
6. Answer any 5 out of the given 6 questions (1 x 5 = 5 marks)
i. Write down full form of FNAC.
a) Fine needle aspiration cytology
b) Free needle aspiration cytology
c) Fine needle activation cytology
d) Free needle activation cytology
ii. is used strictly for taking materials from endocervix.
a) Endo-cervical brush
b) Exo-cervical brush
c) Endocellular brush
d) Extracellular brush
iii. It is important that no air-drying occurs prior to -.
a) Fixation
b) Dehydration
c) Clearing
d) sterilizing
iv.

Identify the given instrument-
a) Cryopreservative bath
b) Plasma thawing bath
c) Cytospin
d) Platelet agitator
v. Name one routine fixative that was originally recommended by Papanicolaou.
Ans: Ether alcohol mixture
vi. Cell blocks are made from
a) all fluid aspirates
b) all epithelial tissues
c) tissue from lumps and lesions
d) reticulocyte cells
SECTION B: SUBJECTIVE TYPE QUESTIONS
Answer any 3 out of the given 5 questions on Employability Skills in 20 – 30 words each (2 x
3 = 6 marks)
7. Describe any 2 steps of active listening?
Ans:
- CONTACT—connect with the participant who is contributing; eye contact, open posture, and nonverbal responses.
- ABSORB—take in all aspects of the spoken message, implicit and explicit, and nonverbal clues. Do not judge or evaluate.
- REFLECTIVE FEEDBACK—mirror, reflect, or provide feedback on what you have heard and why the contributor claims it to be valid.
- CONFIRM—receive confirmation from the speaker that you heard the participant’s message accurately. If not, start the method over again at the beginning by having the speaker restate their view.
8. Give any two of Big Five factors of personality.
Ans:
- OpennessÂ
- ConsciousnessÂ
- Extraversion management
- Agreeableness Skills
- Neuroticism
9. Entrepreneurship is considered to be both an art and a science. Why?
Ans: Entrepreneurship is the perfect combination of art and science, as it requires specific progression and procedures to be followed, and also the skill to digress when required, and yet make the entire activity profitable and growth-oriented.
10. Mention any two ways of minimizing waste and pollution.
Ans:
- Reusing scrap material. For example, in paper mills, damaged rolls are sent back to the beginning of the production line, i.e., they are added as raw material. In the manufacture of plastic items, off-cuts and scrap are re-incorporated into new products.
- Ensuring quality control. If the quality of products is maintained, there will be a decrease in rejected products, thus reducing waste. Automated monitoring equipment is now being used, which can help identify production problems at an early stage.
- Waste exchange: This is where the waste product of one process becomes the raw material for another. It represents the way of reducing waste disposal through reuse.
- Managing e-waste. With advanced technology, we have also encountered problems in managing e-waste like old mobile phones, laptops, and television sets. It is important to have sustainable development and plan judiciously for recycling e-waste.
- Use of eco-friendly materials. Scientists have discovered various materials, which are eco-friendly, for example, banana leaf and paper plates that are easily disposable. These must be made easily available, and their use needs to be encouraged.
11. Differentiate between a worksheet and a workbook.
Ans:
- A worksheet is a collection of cells in the form of a grid (a network of lines that intersect each other, making rectangles). When you open a spreadsheet for the first time, you see a blank worksheet with the name ‘Sheet1’.
- A workbook is a spreadsheet that has one or more worksheets.
Answer any 3 out of the given 5 questions in 20 – 30 words each (2 x 3 = 6 marks)
12. Write down the advantages of Evacuated Tube System.
Ans:
- Adequate sample is ensured (vacuum in the tube controls the amount of blood entering the tube).
- The correct ratio of anticoagulant to blood is ensured.
- This is a closed system and spillage of blood, and hence any Biohazard is thus avoided.
- Large amounts of blood (in multiple tubes) can be collected with minimum discomfort to patient.
13. Give the principle of Sahli’s method used for haemoglobin estimation.
Ans: Haemoglobin is converted to acid haematin by the addition of N/10 or 0.1 N hydrochloric acid, and
the resulting brown colour is compared with standard brown glass reference blocks. The intensity of the brown colour depends on the amount of acid haematin, which in turn, is proportional to the amount of haemoglobin in the blood sample.
Protein, lipid, bilirubin, methaemoglobin, carboxy-haemoglobin, and sulfhaemoglobin influence the depth of colour. Acid haematin is in colloidal suspension and so cannot be used in the photometer or colorimeter, which requires optically clear solutions.
14. Write down the importance of blood storage cabinets.
Ans:
- Uniform temperature between 2°C–6 °C (in AC room)
- Stainless steel inner chamber and an Inside acrylic door to avoid temperature loss
- Digital temperature indicator cum controller with audio visual alarm
- Full-view glass doors for observation without disturbing the inside conditions.
15. Explain two types of materials used to detect respiratory tract malignancies.
Ans:
Sputum Cytology: Sputum specimen can be obtained from the patient either spontaneously or by aerosol–induced method. Morning specimen resulting from overnight accumulation of secretion yields the best results. Three to five consecutive days’ sputum samples should be examined to ensure maximum diagnostic accuracy. The sputum must be carefully inspected by pouring the specimen into a petri dish and examining it on a dark background. Select any bloody, discolored, or solid particles, if present, place a small portion of each particle on a micro slide, spread evenly, and fix it immediately.
Bronchoscopic Specimens: Specimens that are obtained by bronchoscopy are secretions (bronchio-alveolar lavage), direct needle aspirate from a suspicious area, and bronchial brushing and washings. Post-bronchoscopic sputum is one of the most valuable specimens for the detection of pulmonary lesions.
16.
Differential leukocyte count is done to estimate the percentage of different types of WBC’s in blood. What are the various sources of error while performing a differential count?
Ans: Endometrial aspiration smear: After preliminary visualization and cleaning of the cervix, a sterile cannula is introduced into the uterine cavity, and aspiration is then carried out with a syringe. The specimen is squirted on a clean glass slide, gently spread, and rapidly fixed.
Answer any 2 out of the given 3 questions in 30– 50 words each (3 x 2 = 6 marks)
17. Enumerate three stages of the ESR experiment.
Ans: Sedimentation is defined as the settlement of red cells to the bottom with an upper plasma layer when anti-coagulated blood is kept undisturbed for a period of time. There are three stages in which this occurs:
- 1) The stage of aggregation – This is the first stage when the red cells form rouleaux and is the most important stage in sedimentation.Â
- 2) Stage of sedimentation – is the phase of actual falling of the cells. The larger the aggregates formed in stage I, the faster the rate of fall. This is related to both weights to surface area.Â
- 3) The stage of packing is the final one when individual cells and aggregates slow down due to crowding.
18. What are the different types of blood collection bags used in blood banks? Describe the role of tube sealer while collecting blood in bags.
Ans: There are different varieties of bags; they are single, double, triple, or quadruple.
- Single bag: does not have any satellite bags.
- Double, triple, and quadruple bags have one, two, and three satellite bags, respectively.Â
- Quadruple bags are also called buffy coat bags and are used for separating the buffy coat while preparing the blood components. The bags contain the anticoagulant solution: CPD / PCD – A / SAGM.
19. Enlist the indications of FNAC. Outline its methodology.
Ans: INDICATIONS:
- Aspiration is done using disposable needles of 21 gauge (external diameter approximately 0.6-1.0mm) attached to a 20ml syringe.
- The FNAC needles are available in a variety of lengths. Lengths of up to 1/2 inches are found to be adequate for most palpable masses. The 3 1/2-inch 22-gauge disposable needle is used for deep-seated soft-tissue masses.
- Ultrasound or computerized tomography (CT) guidance can be utilized whenever indicated.Â
METHODOLOGY:
- Taking all aseptic precautions, the lump is palpated and localized, and the site of puncture is determined.Â
- The lump is then immobilized with the left hand in a position favorable for needle aspiration and holding the syringe by the barrel in the right hand; the needle is pushed into the predetermined site of the lump until the needle tip penetrates the center of the lump.Â
- The plunger of the needle is then retracted backward to create a negative pressure inside the syringe and needle bore; and without withdrawing the needle through the skin, the syringe is rotated and moved in and out through the lump whilst negative pressure sucks cells into the lumen of the needle.Â
- In order to obtain sufficient material, particularly from fibrotic lesions, the needle is moved back and forth three or more times and directed into different areas of the tumor.Â
- Throughout this manipulation, negative pressure is maintained in the syringe by keeping the piston retracted.Â
- After completion of the aspiration, the pressure in the syringe is allowed to equalize before the needle is withdrawn from the lesion.Â
- This is achieved by releasing the piston of the syringe. After the needle had been withdrawn, the syringe was disconnected from the needle, filled with air, and reconnected.Â
- The material in the needle is expelled onto a glass slide, care being taken to deposit it as a single drop at one end of the slide.Â
- The needle tip is then brought into light contact with the slide, and the aspirate is carefully expressed from it.Â
Answer any 3 out of the given 5 questions in 50– 80 words each (4 x 3 = 12 marks)
20. How can the microscope be handled properly in the laboratory?
Ans: This instrument helps us to examine tiny objects that cannot be visualized with the naked eye. It is a delicate instrument and needs utmost care.
- a) Cleaning of the objective and eyepiece should be done regularly, and they should be kept free from dust. The optical part is cleaned to remove grease using a soft cloth or lens paper.
- b) Hold the microscope firmly while moving it to prevent the lenses from dropping down.
- c) Exposure to sunlight should be avoided, and it should be kept at room temperature.
- d) After one uses oil immersion, one must always clean the oil from the objective.
21. How can the bleeding time be measured by the IVY method?
Ans: The following steps are followed to measure bleeding time:
- A BP cuff is placed on the patient’s arm about 2 to 3 inches above the elbow joint. Pressure is increased to 40 mm Hg. This pressure is kept for the entire procedure.
- An area is selected on the volar surface of the forearm (devoid of any superficial veins) and cleaned with a spirit swab. The area is allowed to dry, and there will be 2 skin punctures, 5 – 10 cm apart, 2.5 mm deep, mm wide, and the stopwatch is started.
- Blood is blotted from each puncture site on a piece of filter paper every 15seconds. The filter paper should not touch the wound. (As this may interfere with the process of platelet plug formation). When bleeding stops, the watch is stopped, time noted, and the BP cuff is released.
- Bleeding times of the two puncture sites are noted, and the average of the two results is reported.
22. Reema is working in the cytology laboratory of a reputed hospital. What kind of safety rules shall be followed by her in the laboratory?
Ans: Hair should be tied back neatly, away from the shoulders.
- The lab should be well-ventilated and should strictly follow the regulations governing the acceptable limits of the reagents used.
- If solvents are used during practical sessions, the exhaust fan must be switched on.Â
- Whenever doing staining procedures, ensure that protective gowns, gloves, and safety glasses are worn.Â
- Inspect centrifuge tubes for cracks.Â
- Never pipette samples with your mouth.Â
- A safety data sheet should be maintained for every chemical compound used, and it should specify the nature, toxicity, and safety precautions to be taken while handling the compound.Â
- Proper disposal of hazardous wastes is a must.Â
- Every instrument used in the laboratory should meet electrical safety specifications and have written instructions regarding its use.
23. Describe in detail any four sampling devices used by professional medical personnel for preparation of FGT smear.
Ans: Sampling Devices: The collection device may play an important role in sample adequacy. The shape, surface, texture, and material of the device may determine how much of the scraped material is deposited onto the glass slide and is available for screening and analysis. Several methods of obtaining cytologic material from the uterine cervix are available.
However, the use of a cotton swab for the collection of cervical smear is to be discouraged, in view of the drying artifacts and loss of cells, which are caused by this method. Smears obtained with the original Ayre’s spatula are often easier to screen. A wooden spatula is preferable to a plastic spatula because of its mildly rough surface that can collect more material. The disadvantages are that the method may occasionally be traumatic to the patient, and the tip of the spatula may not fit the external or may fail to remove some of the valuable material from the squamo-columnar junction.
- The endocervical brush is a small, bottlebrush-like device with one end featuring fine nylon bristles. This device is strictly for taking materials from the endocervix.
- Gently insert the brush into the endocervix and rotate one turn, pressing in the upper and lower walls. The cytobrush is similar to that of an endocervical brush except that the projected tip is without bristles. This can be used for obtaining cells from the whole cervix. Single sampling devices and methods have their limitations in obtaining adequate smears from the cervix. A combination of two devices, usually a spatula and an endocervical brush, gives better results. The triple smear or the vaginal-cervical-endocervical (VCE) technique can provide the best results. However, feasibility and cost factors need to be taken into consideration.
- In postmenopausal women. The squamo-columnar junction recedes, making it difficult to obtain a good
- amount of endocervical cells and cells from TZ. Hence, a combination of two devices, a spatula plus an endocervical brush, is preferred.
24. Enumerate the functions of four special-purpose fixatives.
Ans:
- Carnoy’s fixative: This is a special-purpose fixative for haemorrhagic samples. The acetic acid in the fixative haemolyses the red blood cells. It is an excellent nuclear fixative as well as preservative for glycogen, but results in considerable shrinkage of cells. Carnoy’s fixative must be prepared fresh when needed and discarded after each use. It loses its effectiveness on long standing, and chloroform can react with acetic acid to form hydrochloric acid.Â
- AAF Fixative: This is the ideal fixative used for cellblock preparation of fluid specimens.Â
- Saccomanno collection fluid: A green coloured fixative of the collection of sputum.Â
- Cytolyt solution: This is a clear water-based buffered fixative for the collection of fluid specimens. A 50:50 ratio of specimen to fixative is appropriate (if this is unavailable, use 50% alcohol).
Class 12 Medical Diagnostics Sample Paper 2026 Solved
Here is the CBSE Class 12 Medical Diagnostics Sample Paper 2026 solved in PDF format. Click the button to view the PDF.
Additional Study Materials
- Medical Diagnostics Sample Paper 2025
- Medical Diagnostics Sample Paper 2024
- Medical Diagnostics Sample Paper 2023
- Medical Diagnostics Question Paper 2025
- Medical Diagnostics Question Paper 2024
- Medical Diagnostics Question Paper 2023




